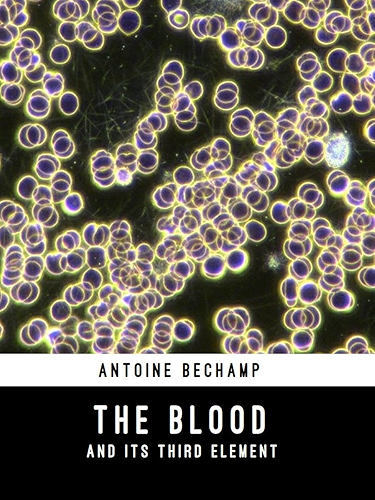

[Télécharger] The Blood and its Third Element (English Edition) de David Major Livres Pdf Epub
Télécharger The Blood and its Third Element (English Edition) de David Major Livres Pdf Epub
Télécharger "The Blood and its Third Element (English Edition)" de David Major Livre PDF Gratuit
Auteur : David Major
Catégorie : Boutique Kindle,Ebooks Kindle,Ebooks en langues étrangères
Broché : * pages
Éditeur : *
Langue : Français, Anglais
During his long career as an academic and researcher in nineteenth century France, Antoine Béchamp was widely known and respected as a teacher, an academic, and a researcher. As a leading academic, his work was well documented in scientific circles. Few made as much use of this fact as Louis Pasteur, who based much of his career on plagiarising and distorting Béchamp’s research. In doing so, Pasteur secured for himself an undeserved place in the history of medical science. The Blood and its Third Element is Béchamp’s explanation of his position, and his defense of it against Pasteur’s deceptions. This final major work of Béchamp’s embodies the culmination of his life’s research. This book contains, in detail, the elements of the microzymian theory of the organization of living organisms and organic materials. It has immediate and far reaching relevance to the fields of immunology, bacteriology, and cellular biology; and it shows that more than 100 years ago, the germ, or microbian, theory of disease was demonstrated by Béchamp to be without foundation. Reviews "I am LOVING this book! I thought when starting class "Oh great, a hard book to read" but it has totally surprised me, and I am now having a hard time putting it down! Great read for any one just looking to learn more about the body and blood and how things work..." "This is an excellent book for knowledge seekers who do not take anything at face value. It is not an easy-read book but if you take the time to read and re-read you will gain valuable information that can strengthen your knowledge about the human body and all its elements especially the blood. I highly recommend this book for those wishing to expand their health related knowledge base" "...what Dr. Béchamp is describing is a foundational concept. According to his experiments and observations, these tiny particles he named "microzymas" have an active role in sustaining and also in terminating life. Using the syllable "-zyme" (now also used in the word "enzyme") to indicate this principle of causing 'fermentation' (activity) Béchamp searched for and found the same particles and activity even in limestone, apparently from the ancient shelled creatures whose bodies were incorporated into the stone. They still retained their activity" "Best book I've ever read on the fundamental elements of life. Bechamp is one of the geniuses of all time." CONTENTS 1. On the nature of fibrin isolated from the clot or obtained by whipping the blood. - The blood fibrin. - Fibrinous microzymas. 2. On the actual specific individuality of the albuminoid proximate principles. - The albuminoids. - Coagulation. 3. The state of the fibrin in the blood at the moment of venesection. - The fibrin without microzymas. - The haematic microzymian molecular granulations. 4. The real structure of the red blood globule. - The microzymas of the blood globules. - The blood globules in general. 5. The real nature of the blood at the moment of bleeding. - The living parts of the blood protoplasm. 6. The real chemical, anatomical and physiological meaning of the coagulation of the shed blood. - Coagulation of the blood. 7. The blood is a flowing tissue and therefore spontaneously alterable. - Pasteur and the germs of the air. 8. The microzymas and bacteriology.
Télécharger The Blood and its Third Element (English Edition) de David Major En Ligne
The Blood and its Third Element (English Edition) eBook ~ Achetez et téléchargez ebook The Blood and its Third Element (English Edition): Boutique Kindle - Bacteriology : Amazon
Amazon - The Blood and Its Third Element - Bechamp ~ Noté /5. Retrouvez The Blood and Its Third Element et des millions de livres en stock sur Amazon. Achetez neuf ou d'occasion
Google Livres ~ Livres. Effectuez des recherches dans l'index de livres complets le plus fourni au monde. Ma bibliothèque. Éditeurs À propos Confidentialit é Conditions d'utilisation Aide .
Blood Tome 03 Télécharger Lire en Ligne PDF EPUB Gratuits ~ Télécharger Gratuits Blood Tome 03 Lire en Ligne en PDF ou EPUB sur 178.128.199.70.DSL.DYN.FORTHNET.GR
Telecharger Livre de sang (Book of Blood) Dvdrip Uptobox ~ Livre de sang (Book of Blood) Annee de production: 2009 Genre: Epouvante-horreur Qualité Dvdrip French. 01h40min. Mary, une enseignante spécialisée en parapsychologie, recrute un de ses étudiants pour qu'il communique avec un adolescent assassiné il y a quelques années dans une maison aujourd'hui abandonnée.
Télécharger blood » Site de Téléchargement Gratuit ~ Télécharger blood. Telecharger "blood" [Direct] blood of Redemption. August 12, 2013, 10:36 pm . Blood.Of.Redemption.2013.FRENCH.DVDRiP.XViD-STVFRV Qualité DVDRiP / FRENCH Production 2013 Réalisé par Giorgio Serafini Avec Billy Zane, Dolph Lundgren, Vinnie Jones, Robert Davi Genre Action, Policier, Thriller Durée 1h 25min Nationalité U.S.A. Alors qu'il mène une vie de privilégié .
Télécharger blood vol.1 » Site de Téléchargement Gratuit ~ Télécharger blood vol.1. Telecharger "blood vol.1" [Direct] blood vol.1 [TRUEFRENCH] [DVDRIP] January 3, 2013, 12:44 am. Blood+.VOL01.TrueFrench.DvdRip.xvid.AC3-PARADIS Blood + Vol.1 Auteur(s): FUJISAKI Jun'ichi tudio(s) : Production I.G. Sony Pictures Animation Aniplex Type :: Série Genre: Horreur,Fantastique Editeur: Black Box Code EAN: 3760000570299 Date de sortie: 16 Decembre 2011 .
Télécharger Blood, tome 1 Livre PDF Gratuit - PDF Complet ~ Télécharger Blood, tome 1 Livre PDF Gratuit. La quatrième de couverture nous promettait la révélation fantasy de lannée et nous présentait Anthony Ryan comme le nouveau Gemmel son livre comme « une épopée flamboyante et lyrique qui laissera sa marque sur le genre de la fantasy moderne » Résumé Etudiante le jour serveuse dans un bar la nuit ma vie nest pas des plus trépidantes .
télecharger le livre Blood Song (The Blood Singer Novels ~ Blood Song (The Blood Singer Novels Book 1) (English Edition) le livre pdf en ligne [PDF] Blood Song (The Blood Singer Novels Book 1) (English Edition) résumé de chaque chapitre détaillé Télécharger Blood Song (The Blood Singer Novels Book 1) (English Edition) Ebook / LIRE EN LIGNE Télécharger en cliquant ici Télécharger epub Blood Song (The Blood Singer Novels Book 1) (English .
Blad blood tome 7 - Document PDF ~ Télécharger le PDF (70,42 . Yo J'ai un bug avec mon téléphone. j'aime pas lire sur l'ordi mais comme j'ai un controle sur un livre de 1 pages la semaine prochaine. BAPTISTE Date d'inscription: 11/05/2018. Le 06-05-2018. Bonsoir J'aimerai generer un fichier pdf de facon automatique avec PHP mais je ne sais par quoi commencer. Est-ce-que quelqu'un peut m'aider ? Donnez votre avis sur ce .
Amazon - The Blood and Its Third Anatomical Element ~ Noté /5: Achetez The Blood and Its Third Anatomical Element: (1912) de Bechamp, A.: ISBN: 9781564597120 sur amazon, des millions de livres livrés chez vous en 1 jour
In the Blood - Dernier livre de Margaret Kirk ~ Précommandez In the Blood à la Fnac, un marchand français. Des milliers de livres avec la livraison chez vous en 1 jour ou en magasin avec -5% de réduction.
Les livres de la collection : Books of Blood - Decitre ~ Découvrez tous les livres de la collection Books of Blood. Livres, papeterie et produits culturels sur decitre, 3ème libraire sur Internet avec un million de livres disponibles
Download Blood / DOS Games Archive ~ Aerosol hairspray can be frightening enough on its own, but apply it to a lighter flame and you've got an instant flamethrower (kids, don't try this at home!). Likewise, a flare gun can brighten your prospects considerably against even the grimmest odds, which is to say nothing for shotguns, Tommy guns, and dynamite. Who knows, you may even find that there are some spirits on your side when .
The Blood and its Third Element: Amazon: Antoine ~ The Blood and its Third Element: Amazon: Antoine Bechamp: Libros en idiomas extranjeros. Saltar al contenido principal. Prueba Prime Hola, Identifícate Cuenta y listas Identifícate Cuenta y listas Pedidos Suscríbete a Prime Cesta. Todos los departamentos . Ir Buscar Hola Elige tu .
Blood Match A Blood Type Novel - ebook (ePub) - K.A. Linde ~ A Blood Type Novel, Blood Match, K.A. Linde, Loveswept. Des milliers de livres avec la livraison chez vous en 1 jour ou en magasin avec -5% de réduction .
The Book of Blood From Legends and Leeches to Vampires and ~ From Legends and Leeches to Vampires and Veins, The Book of Blood, HP Newquist, HMH Books for Young Readers. Des milliers de livres avec la livraison chez vous en 1 jour ou en magasin avec -5% de réduction .
Série Blood Song (4 Tomes) - Ebooks Gratuit : Livres Pdf ~ Ebooks Gratuit > [Audio] Anthony Ryan - Série Blood Song (4 Tomes) - des livres électronique PDF Doc Epub gratuits en francais et libre de droit, Ebooks Romans-Magazines-Manuels et revues de sujets différents
Blood Lad Tome 15. de Yûki Kodama - Tankobon - Livre - Decitre ~ Découvrez sur decitre Blood Lad Tome 15 par Yûki Kodama - Éditeur Kurokawa - Librairie Decitre
The Blood, Fire, and Power - ebook (ePub) - Evangelist ~ The Blood, Fire, and Power, Evangelist Mark C Martel, WestBow Press. Des milliers de livres avec la livraison chez vous en 1 jour ou en magasin avec -5% de réduction .
Blood Song Tome 3. La reine de feu de Anthony Ryan - Grand ~ Découvrez sur decitre Blood Song Tome 3 La reine de feu par Anthony Ryan - Éditeur Bragelonne - Librairie Decitre
Télécharger blood Rapide - Téléchargement Gratuit ~ Télécharger blood [Telecharger] "blood" blood of Redemption. Date: January 15, 2014, 1:56 am. Blood.Of.Redemption.2013.FRENCH.DVDRiP.XViD-STVFRV Qualité DVDRiP / FRENCH Production 2013 Réalisé par Giorgio Serafini Avec Billy Zane, Dolph Lundgren, Vinnie Jones, Robert Davi Genre Action, Policier, Thriller Durée 1h 25min Nationalité U.S.A. Alors qu'il mène une vie de privilégié, grâce .
Blood Lad Tome 3. de Yûki Kodama - Tankobon - Livre - Decitre ~ Découvrez sur decitre Blood Lad Tome 3 par Yûki Kodama - Éditeur Kurokawa - Librairie Decitre
Books of blood - etsy ~ Etsy a recours à des cookies et autres technologies similaires pour vous fournir une meilleure expérience. Cela permet des choses telles que : le fonctionnement d'outils basique
Telecharger Blood and Bone Dvdrip Uptobox 1fichier ~ Blood and Bone. Annee de production: 2009 Genre: Drame Qualité Dvdrip French. 1h30 min . Fraîchement sorti de prison, Bone arrive dans les bas-fonds de Los Angeles où il fait la connaissance de James, un parrain de la drogue et de la prostitution qui ne recule devant aucune méthode pour se faire respecter.
Comments
Post a Comment